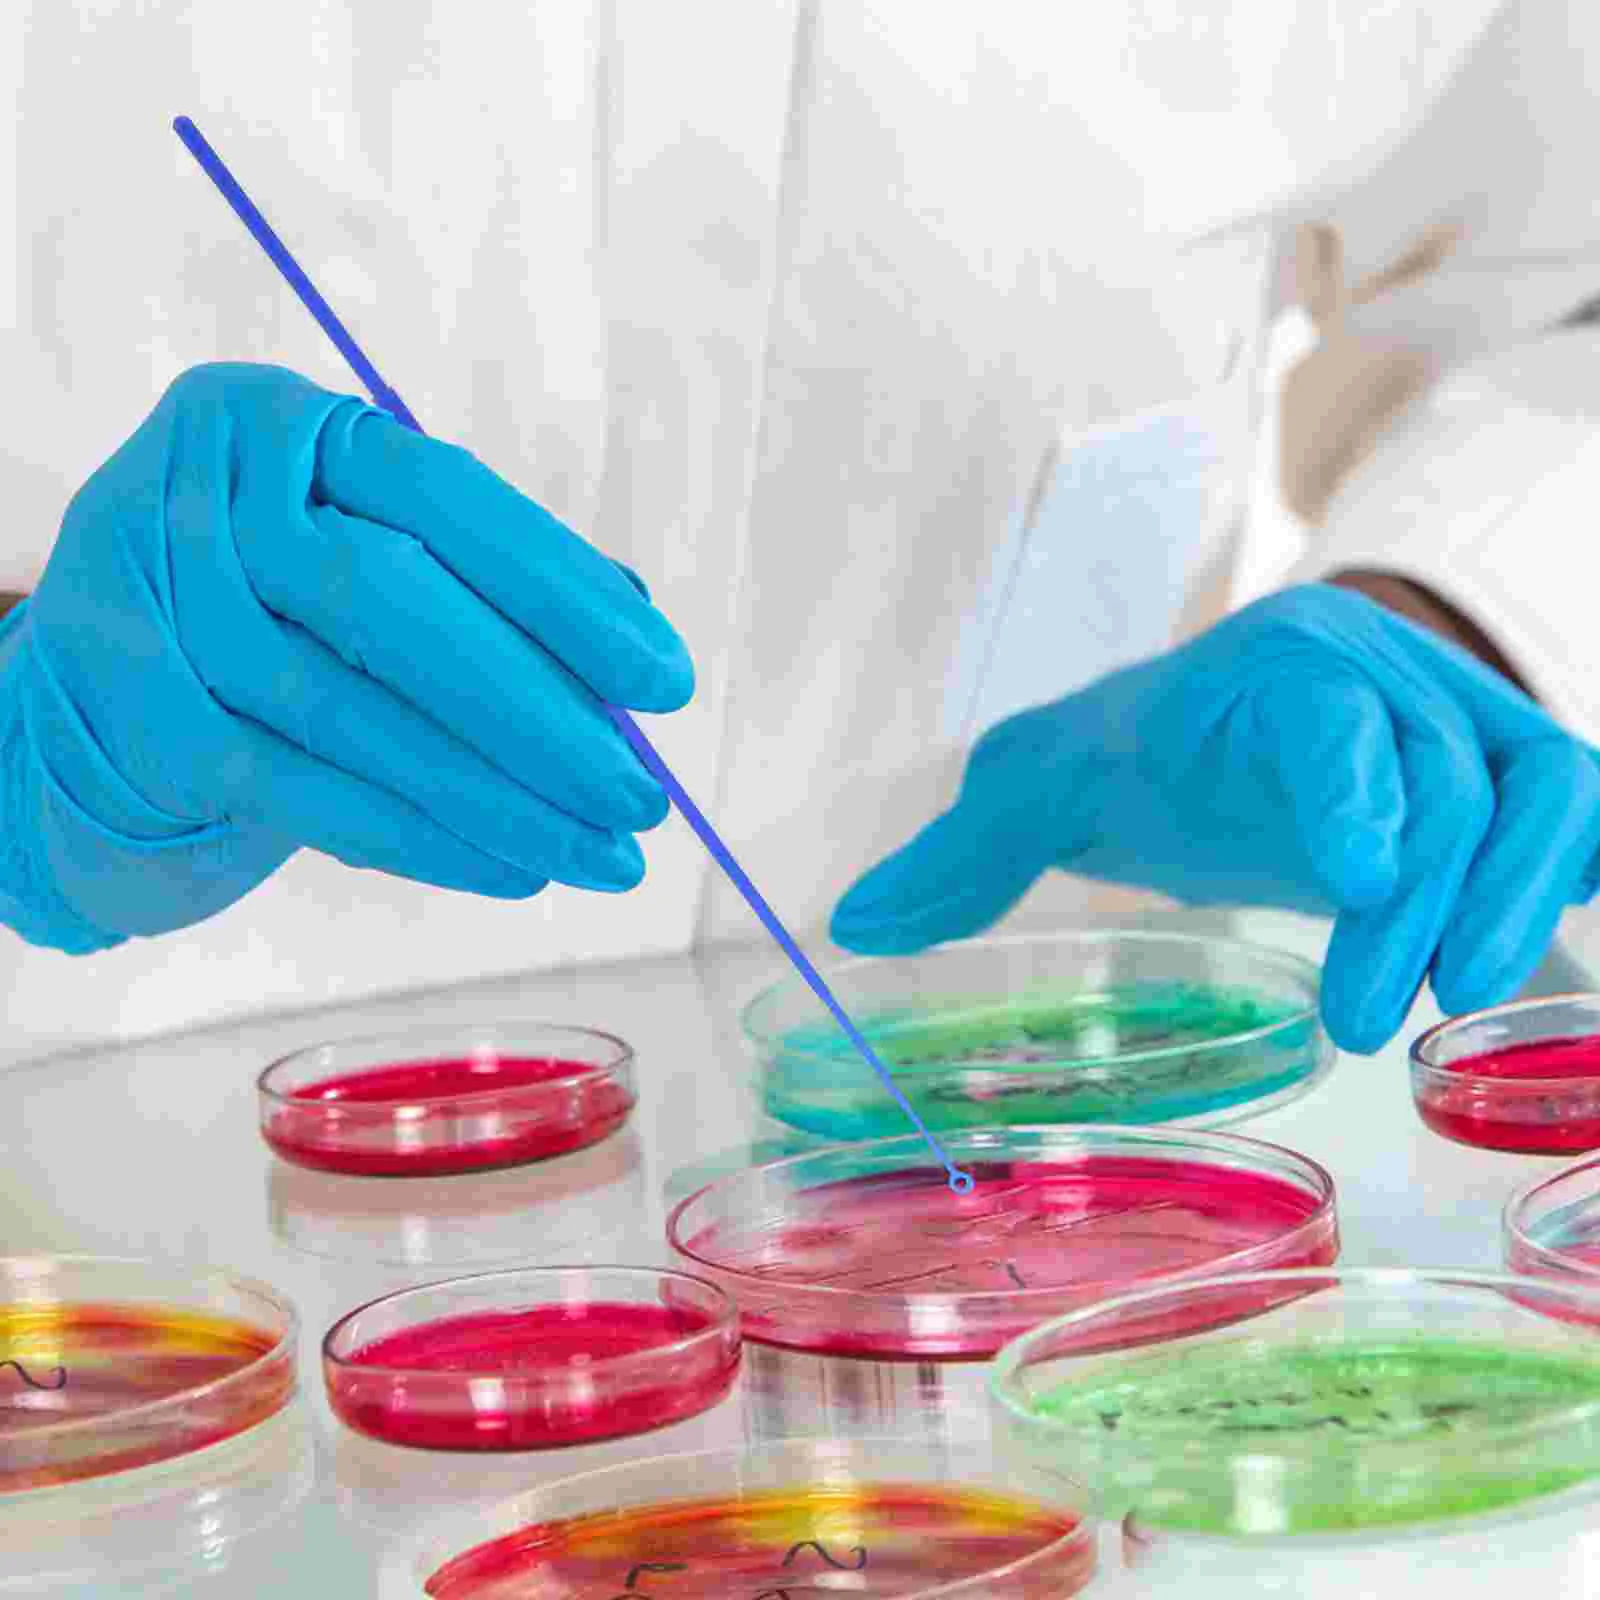
thumb

20 Pcs Inoculating Stick Experiment Tools Inoculation Microbiology Device Laboratory Loop Rings Rod Parts The Hips
Price history chart & currency exchange rate
Customers also viewed

$3.15
Sheep Horn Headband Black Single Claw Hair Bands Women Party Demon Decorations Cosplay Accessories Sturdy Materials Long Lasting
aliexpress.ru
$17.56
4 Pcs Christmas Snowflake Ornament Tree Ornaments Hanging Gift Decoration Plastic Xmas Small Pendant
aliexpress.com
$6.21
10 Pcs Rubber Cone Shape Desk Feet Protector Chair Leg Tip Pad With 12 Pcs Blanking End Round Tube Inserts Cap Cover
aliexpress.com
$19.82
Side Brush Filter Mop Cloth Spare Parts Accessories For Roborock S8 Pro Ultra S8 S8+ Robot Vacuum Cleaner
aliexpress.com
$234.85
BSWolf виниловый тент с навесом для улицы, кемпинга, пикника, бабочки, шестиугольный тент большого размера, 520, утренний туман, белый
cdek.shopping
$22.86
2023 75th custom mens womens denver''nuggets''allen 3 iverson petr 21 cornelie alex 2 english dikembe 55 mutombo basketb, Black;red
dhgate.com
$1,013.80
white inflatable led cube p booth pbooth room cabin studio house with rgb lights for advertisements and events
dhgate.com
$2.92
women's panties summer underpant seamless triangle girls briefs shorts cool refreshing female underwear, Black;pink
dhgate.com
$45.83
women's vests formal ladies dark blue striped vest women waistcoat slim elegant work wear clothes fashion office uniform styles, Black;white
dhgate.com$287.83
Компьютер VINGA Advanced A0333 (R3M16R550.A0333), Advanced A0333 (R3M16R550.A0333)
foxtrot.com.ua
$25.59
remote controlers 2.4ghz learning mini wireless keyboard air mouse ir control with usb receiver for smart tv android box fire
dhgate.com
$60.35
cat nest four seasons универсальный villa cat house съемные вертикальный гофрокартон скретч rattan болл cat поставки
dhgate.com
$2.20
20 шт., прочные металлические заколки для невесты, аксессуары для укладки, женские свадебные заколки для волос, свадебные заколки для невесты, длинный пучок для волос
aliexpress.ru
$8.47
Green Leaf Print Maxi Dress XS-3XL Drape Neck Sleeveless Bodycon Style for Garden Wedding, Spring Brunch or Nature Retreat Look
aliexpress.ru
$27.77
Мужские шлепанцы Бали Regatta, мультиколор, Черный, Мужские шлепанцы Бали Regatta, мультиколор
cdek.shopping
$21.22
Корейский дизайн, трикотажный топ без рукавов с узором из конопли, утягивающий талию русалки, женская одежда, новый элегантный универсальный трикотаж 2025
aliexpress.ru
$8.74
Современные игрушки для ванной для малышей 1-3 лет, игрушки для водяной ванны с мини-разбрызгивателем и чашками
aliexpress.ru
$15.25
Джинсовая юбка больших размеров с низкой талией, женская летняя облегающая юбка трапециевидной формы Y2K Spicy Girl, корейская юбка Sle Commute Faion
aliexpress.ru
$17.66
Новинка 2025, мужская футболка Mizuno Inoue Naoya, ограниченная серия, спортивный топ с короткими рукавами, быстросохнущий, впитывающий пот, антибактериальный топ с принтом
aliexpress.ru